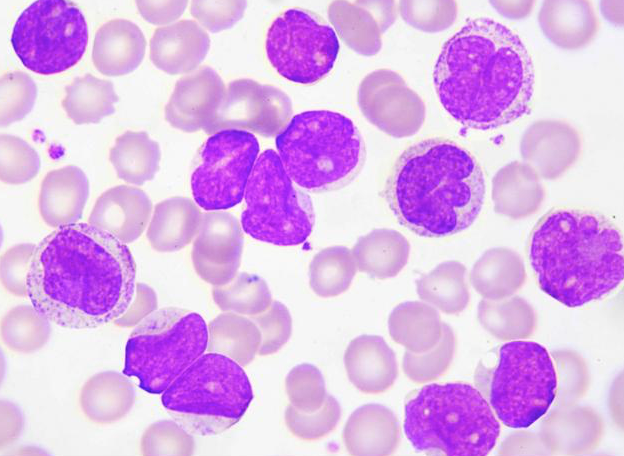

隨著HPV疫苗的不斷普及,女性對(duì)于HPV病毒的關(guān)注度越來(lái)越高,因?yàn)榕栽谟辛诵陨詈?,患上HPV病毒的概率是非常大的。
據(jù)不完全統(tǒng)計(jì),在全球范圍內(nèi),大約每5個(gè)女性,就會(huì)有1人感染上HPV病毒,所以該病毒的感染率并不低。
而且女性在感染了HPV病毒后,如果一直處于高危狀態(tài),那么很有可能會(huì)導(dǎo)致子宮頸癌的出現(xiàn),因此大多數(shù)女性對(duì)于HPV病毒,可以說(shuō)是談之色變的態(tài)度。
所以當(dāng)身體出現(xiàn)以下這幾個(gè)表現(xiàn)的時(shí)候,最好及時(shí)去醫(yī)院進(jìn)行HPV病毒的排查,以防意外出現(xiàn)。

一、白帶出現(xiàn)異常
白帶可以說(shuō)是女性健康的晴雨表,這是因?yàn)樽訉m頸在出現(xiàn)問(wèn)題的時(shí)候,陰道排液就會(huì)隨之發(fā)生改變。所以當(dāng)白帶出現(xiàn)異常表現(xiàn)的時(shí)候,可能就存在HPV病毒感染的概率。
通常感染了較為輕微的HPV病毒時(shí),白帶會(huì)出現(xiàn)水樣或者增多的情況,隨著感染的加重,白帶可能會(huì)出現(xiàn)血絲,甚至伴隨著較為難聞的腥臭味。

二、陰道出血
很多HPV病毒感染者,都會(huì)伴隨著陰道出血的表現(xiàn),這種出血主要是指接觸性出血和不規(guī)則的非接觸性出血。
所謂的接觸性出血,主要是指女性在性生活后,陰道會(huì)出現(xiàn)血性白帶或鮮血。不規(guī)則的非接觸性出血,則是指女性在非經(jīng)期,絕經(jīng)后的不規(guī)則陰道出血。

三、陰道內(nèi)外出現(xiàn)疣體
有些女性會(huì)發(fā)現(xiàn)自己外陰或者陰道,長(zhǎng)出了很多小痘痘,這被稱之為疣體。通常在剛剛發(fā)現(xiàn)的時(shí)候,疣體并沒(méi)有過(guò)于明顯的表現(xiàn),可能只是尖頭小丘疹。
但隨著疣體數(shù)量的不斷增多,往往會(huì)形成菜花狀,并伴隨較為強(qiáng)烈的瘙癢,而且很容易出血,甚至?xí)霈F(xiàn)比較難聞的異味。

通常在出現(xiàn)以上表現(xiàn)的時(shí)候,就需要及時(shí)去醫(yī)院進(jìn)行HPV的檢查,因?yàn)檫@是由HPV感染后,產(chǎn)生的尖銳濕疣。
如果不加以處理的話,疣體會(huì)逐漸增大,會(huì)覆蓋陰道內(nèi)外的全部皮膚表層,甚至蔓延到肛周附近。

四、腹部出現(xiàn)疼痛
如果女性在非經(jīng)期,小腹出現(xiàn)不規(guī)則的疼痛感,那么需要引起重視。因?yàn)樵诔霈F(xiàn)HPV病毒感染后,子宮頸有可能已經(jīng)出現(xiàn)了一定的病變,所以才會(huì)產(chǎn)生較為明顯且不規(guī)則的腹痛。
特別是在出現(xiàn)腹痛的時(shí)候,如果還伴隨著白帶異常,明顯的腥臭味,那么就要及時(shí)的進(jìn)行檢查,看看是否存在高危型HPV的感染。因?yàn)楹芏嘧訉m頸癌的出現(xiàn),都是因?yàn)楦腥玖?6型,18型等高危型病毒,所以才會(huì)出現(xiàn)腹部疼痛等癥狀。

如果女性身體出現(xiàn)了以上這4個(gè)特征,最好盡早前往醫(yī)院進(jìn)行HPV病毒的篩查。特別是已經(jīng)有了性生活或者生育后的女性,定期進(jìn)行TCT以及HPV病毒的篩查,將對(duì)健康非常有利。
如果有條件的話,還可以根據(jù)年齡的劃分,進(jìn)行HPV疫苗的注射,這對(duì)于預(yù)防子宮頸癌的出現(xiàn),會(huì)有很大的幫助。
來(lái)源:新浪微博 醫(yī)說(shuō)健康
(文章部分圖文來(lái)源于網(wǎng)絡(luò),版權(quán)歸原作者所有,如有侵權(quán),請(qǐng)聯(lián)系醫(yī)院刪除)
微信掃碼預(yù)約

吉公網(wǎng)安備 22038102000293號(hào) 吉ICP備18000181號(hào)